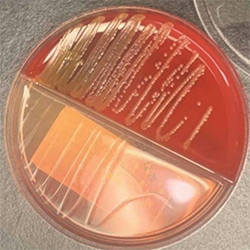

Pneumonia encompasses a broad range of infections affecting not only the lung parenchyma caused by bacteria and viruses but also fungi in immunocompromised populations. Despite modern antimicrobial therapy, pneumonia remains a global health burden, accounting for millions of hospitalizations annually and high mortality rates in severe cases.1-3
A critical challenge in pneumonia management is appropriate diagnosis and determination of the etiologic agent. In a recent multicenter study, 1 in 8 patients were inappropriately diagnosed with community-acquired pneumonia (CAP), mostly due to conflicting clinical presentations,4 because of nonspecific clinical presentations, overlapping radiographic findings, underlying comorbid conditions that confounded the picture,5 and frequently initiated empiric antibiotics. Overuse of broad-spectrum antibiotics contributes to antimicrobial resistance, microbiome disruption, and Clostridioides difficile infection; meanwhile, delayed recognition of fungal or atypical pathogens can result in poor outcomes.
Recent advances in rapid diagnostics—particularly nucleic acid amplification tests (NAATs), multiplex polymerase chain reaction (PCR) respiratory panels, and host–response biomarkers—offer opportunities to improve etiologic precision and antimicrobial optimization. This review integrates clinical, microbiological, and biomarker evidence to help clinicians recognize fungal, viral, and bacterial CAP.
Clinical Presentation and Infection-Related Biomarkers
Diagnosis of pneumonia is made by a combination of 2 or more signs or symptoms of pneumonia combined with consistent radiographic findings without an alternative explanation.3 Although the clinical manifestations of pneumonia overlap across etiologies, certain trends can guide initial suspicion. Bacterial pneumonia has an abrupt onset with a high fever, productive cough, and lobar consolidation. Primary viral pneumonia most often has a prodrome with gradual worsening and diffuse infiltrates on radiographic imaging. Fungal pneumonia presents with a more subacute course, particularly in immunocompromised hosts (Table 1), with nodular or cavitary lesions seen on imaging.
| Table 1. Form of Immunosuppression and Associated Fungal Pathogen Risk | |||||||
 |  |  |  |  |  |  | |
|---|---|---|---|---|---|---|---|
| HSCT | × | × | × | × | × | × | × |
| Prolonged neutropenia (=2 wk of an ANC <500) | × | × | |||||
| SOT | × | × | × | × | × | × | × |
| High-dose steroids (=20 mg prednisone =2 wk) | × | × | × | × | × | × | × |
| Hemoglobin A1c =7% | × | ||||||
| TNF-alpha inhibitors | × | × | × | ||||
| Ibrutinib (Imbruvica, Pharmacyclics/Johnson & Johnson) | × | × | |||||
| HIV/AIDS | |||||||
| CD4+ <250 cells/mm3 | × | ||||||
| CD4+ <200 cells/mm3 | × | × | |||||
| CD4+ <150 cells/mm3 | × | × | × | ||||
| CD4+ <100 cells/mm3 | × | × | × | × | × | ||
| ANC, absolute neutrophil count; HSCT, hematopoietic stem cell transplantation; SOT, solid-organ transplantation; TNF, tumor necrosis factor. | |||||||
After clinical presentation has been assessed, objective infection-related biomarkers should be obtained. The primary infection-related biomarkers for diagnosing CAP include C-reactive protein (CRP), serum white blood cell (WBC) count, core body temperature, and procalcitonin (PCT). CRP levels, detected by Abbott AFINION Point-of-Care (POC) CRP, usually rise within 6 to 12 hours of infection and are more elevated in bacterial infections (>100 mg/L).6 Leukocytosis typically favors a bacterial infection, while lymphocytosis suggests a viral infection. However, WBC counts trends—and not single, isolated values—should guide clinical decision-making. An increase in core body temperature can also indicate the presence of a systemic infection.
Distinguishing between types of pathogen is nearly impossible with generic infection-related biomarkers. However, the mean WBC count is significantly lower in patients with Mycoplasma pneumoniae and Chlamydia pneumoniae infections; the body temperature of those with Legionella pneumophila or M. pneumoniae pneumonia is significantly higher than that of patients with Streptococcus pneumoniae infection.7
Procalcitonin is an infection-related biomarker that is more specific for bacterial disease and can be measured by Thermo Fisher Scientific B•R•A•H•M•S Biomarker assays.8 Procalcitonin levels less than0.1 g/L are more indicative of a viral infection; levels of 0.1 to 0.25 g/L are indicative of a bacterial infection beginning or the presence of other chronic conditions; and the likelihood of a bacterial infection increases with levels of at least 0.25 g/L.1 The most prudent use of PCT is in assisting with discontinuing antibiotics in patients who are not clinically stable after 48 to 72 hours of starting antibiotics, which would rely on trends of PCT demonstrating a decrease of at least 80% with respect to the maximum level or absolute terms no more than 0.5 g/L.1,9,10
A diagnostic and treatment algorithm is shown in the Figure.
|
|
|
Figure. Diagnostic and management algorithm. BAL, bronchoalveolar lavage; CAP, community-acquired pneumonia; CBC, complete blood count; CRP, C-reactive protein; PCR, polymerase chain reaction; PCT, procalcitonin. |
Imaging and Pathogen Interpretation
Two main radiographic techniques are used to assist in the diagnosis of CAP: chest x-ray (CXR) and chest CT. CXR is often the initial imaging modality because it is relatively inexpensive and readily accessible. However, the sensitivity (median, 70%; range, 16%-95%) and specificity (median, 55%; range, 0%-94%) vary according to the quality of the image, as well as the ability to compare current with prior images.3 The sensitivity also is lower in immunocompetent patients who have evidence on chest CT but not on CXR (eg, older adults).1
Chest CT is a more sensitive diagnostic imaging technique that is capable of revealing findings suggestive of pneumonia up to 5 days earlier than CXR. It can also assist in differentiating the radiological patterns present, which can aid in determining the etiologic agent.1
Although the radiographical findings may vary pending modality used and immunocompetency of the patient, bacterial, viral, and fungal pneumonias have different imaging results. Findings include:
- bacterial infections with lobar consolidation;
- viral infections with bilateral, diffuse infiltrates; and
- fungal infections with nodular/cavitary lesions (particularly in the upper lobes), halo sign/reverse halo sign, and/or mediastinal lymphadenopathy.11
Overview of Microbiological Diagnostics
Traditional culture-based methods remain the gold standard for identifying the causative pathogen, but they are slow and insensitive, especially for atypical organisms. Modern diagnostics incorporating molecular assays (PCR/NAATs), antigen-based tests, and host–response biomarkers enhance diagnostic accuracy and guide antimicrobial stewardship efforts for optimizing treatment selection and duration (Table 2).6,8,12-20
| Table 2. Selected Rapid Diagnostic Manufacturers and Platforms for Pneumonia | |||
| Manufacturer and platform | Technology | Representative organisms | Notes |
|---|---|---|---|
| bioMérieux BioFire FilmArray Respiratory Panel 2.1 | Multiplex PCR | >20 viral + atypical bacteria | 1-h syndromic panel |
| Cepheid Xpert Xpress | Cartridge RT-PCR | SARS-CoV-2, flu A/B, RSV | POC, 30-45 min |
| Roche cobas eplex | RT-PCR | Viral + atypical bacterial pathogens | 100 min syndromic panel |
| Roche cobas liat | RT-PCR | SARS-CoV-2, SARS-CoV-2 + flu A/B, SARS-CoV-2 + flu A/B + RSV, flu A/B + RSV, or Strep A | 20 min |
| Qiagen QIAstat-Dx Respiratory Panel Plus | RT-PCR | 21 >20 viral + atypical bacteria | 1 hour |
| Abbott ID NOW | Isothermal NAAT | Influenza, SARS-CoV-2 | POC, <15 min |
| Quidel Sofia/BD Veritor Plus System | Antigen immunoassay | Influenza, RSV, SARS-CoV-2 | Rapid, low cost |
| Thermo Fisher Scientific B•R•A•H•M•S PCT | Immunoassay | Procalcitonin (host biomarker) | Bacterial vs viral differentiation |
| Abbott AFINION Point-of-Care CRP | Immunoassay | CRP (host biomarker) | Outpatient triage |
| UATs: Abbott Diagnostics BinaxNOW, Fisher, Quidel Sofia, Trinity Biotech, Diasorin LIAISON | Immunochromatographic | Streptococcus pneumoniae, Legionella pneumophila | High specificity |
| CRP, C-reactive protein; NAAT, nucleic acid amplification test; PCR, polymerase chain reaction; POC, point of care; RSV, respiratory syncytial virus; RT, real-time=; UAT, urinary antigen tests. Based on references 6, 8, 12-22, and 24. | |||
When considering any diagnostic test, ensure there is at least a moderate to high pretest probability of a positive result combined with whether the result will enhance medical management of CAP.3 Less than a moderate to high pretest probability yields suboptimal use of the test, resulting in diagnostic uncertainty.
Molecular Diagnostics (PCR and Multiplex Panels)
PCR-based diagnostics revolutionized pneumonia evaluation by detecting pathogen nucleic acids directly from respiratory samples. These technologies rapidly identify viral pathogens to reduce use of unnecessary antibiotics. However, interpretation of the results requires the clinician to consider colonization versus infection. In addition, best use of the test means determining a plan of action to follow the test results.
Some of the key technologies that can be employed in identifying the causative organism in CAP include the bioMérieux BioFire FilmArray Respiratory Panel 2.1 (detects >20 respiratory pathogens, including viruses and atypical bacteria),12 Cepheid Xpert Xpress Respiratory Test (detects SARS-CoV-2/flu/respiratory syncytial virus (RSV) in approximately 45 minutes with 1 cartridge),13 Roche cobas eplex Respiratory Pathogen Panel 2 (emergency use authorization) and the cobas liat (detects >20 respiratory pathogens, including viruses and atypical bacteria),14,15 Qiagen QIAstat-Dx Respiratory Panel Plus (detects 21 respiratory pathogens, including viruses and atypical bacteria),16 and Abbott ID NOW (detects SARS-CoV-2, influenza A and B, RSV, and S. pyogenes via isothermal amplification within 15 minutes).17 There is also a QIAstat-Dx Respiratory Panel Mini that checks for 5 viral targets, including influenza A and B, RSV, SARS-CoV-2, and human rhinovirus.16 Additionally, the Cepheid Xpert SA Nasal Complete PCR can be employed to screen for community-acquired Staphylococcus aureus colonization status in nasal exudate with an estimated negative predictive value of 98.1% for CAP.1
Emerging fungal PCR assays can enhance sensitivity for detecting Aspergillus and Pneumocystis from both serum and bronchoalveolar lavage (BAL) samples. For Aspergillus, the cell wall galactomannan component is the target for both the serum and BAL samples, with bronchiolar samples having higher sensitivity than serum (~90% bronchiolar vs ~45% serum).11 For Pneumocystis, the organism’s DNA is the target for the bronchiolar samples.10
Bacterial and Viral Antigen Tests
Antigen detection provides fast, low-cost diagnostics for some of the most likely pathogens in CAP. The Quidel Sofia and BD Veritor Plus System detect influenza, RSV, and SARS-CoV-2 within minutes, with a specificity greater than 80% and a sensitivity of 49% to 84%.1,18 The sensitivity is moderate, so true infection should be confirmed with PCR.
Rapid detection of S. pneumoniae and L. pneumophila can greatly alter clinical outcomes of critically ill patients, but such benefit has not been shown for stable CAP patients. Therefore, routine use of urinary antigen tests (UATs) are only recommended in severe CAP cases or in patients with specific risks for those organisms by the American Thoracic Society and Infectious Diseases Society of America (ATS/IDSA) CAP guidelines.9 The UATs are simple, noninvasive, and are not affected by previous administration of antibiotics, with a sensitivity and specificity of 70% and 83%, respectively.2 With the low sensitivity, these tests should be combined with other diagnostics to accurately confirm the presence or absence of S. pneumoniae and L. pneumophila.2
Available S. pneumoniae UATs include the Abbott Diagnostics BinaxNOW S. pneumoniae Urinary Antigen Enzyme Immunoassay (EIA),19 Quidel Sofia fluorescence immunoassay,18 and Trinity Biotech Uni-Gold.20 These tests detect the presence of the C-polysaccharide antigen common to all serotypes of S. pneumoniae and have a sensitivity of approximately 70% and specificity more than 90%, which is a higher sensitivity and specificity than culture.2 However, sensitivity of the UATs has declined since the introduction of 13-valent polysaccharide conjugate vaccine to 40% to 60%.2
Unfortunately, the positive test prevalence is low (4%-15%), so there may be limited opportunities for antimicrobial stewardship interventions.2 Test results usually do not result in a change in antibiotic therapy (~70%), but this may be due to understanding the intricacies of the results rather than the test itself.2 However, in institutions with higher positive test prevalence and higher UAT testing rates, antibiotic therapy is more likely to be altered.2
Available L. pneumophila UATs include the Abbott Diagnostics BinaxNOW Legionella Urinary Antigen EIA21,22 and Quidel Sofia Legionella fluorescent immunoassay.18 Both tests are specific, noninvasive, rapid (15 minutes), and unaffected by antibiotics. The tests mainly target lipopolysaccharide in the cell wall of L. pneumophila serogroup 1, which can lead to false negatives in patients who either do not excrete or excrete the antigen intermittently or in those without severe disease.23 The sensitivity is 55% to 80% (87%-97% from the manufacturer2) with a 100% specificity.23
Although serogroup 1 is most commonly associated with human infection, other serotypes can cause disease. To address the need for testing all serotypes, the Diasorin LIAISON is a fully automated chemiluminescence-based UAT (Legionella Urinary Ag assay) that is designed to detect all Legionella serogroups, as well as multiple non-pneumophila species.24 This UAT may provide better reassurance for the presence of Legionella-related CAP.
Fungal Pneumonia Diagnostics
Fungal CAP, while infrequent in immunocompetent individuals, should be in the differential for immunocompromised patients or in those not responding to antibiotic therapy. There are PCR and antigen tests available to check for most fungal species known for infecting humans.
ACC’s Fungitell is a pan-fungal, noninvasive serum (1->3)-beta-D-glucan assay that can detect a cell wall component present in most Candida, Aspergillus, and Pneumocystis species, but it cannot reliably detect cryptococcosis, blastomycosis, and mucormycosis, as the test will provide a low positive or negative result. It has a positive predictive value greater than 90% and a negative predictive value of 95%.23
PCR tests are available for all fungi; however, only a few are employed on a more frequent basis, such as for detecting Aspergillus or Pneumocystis jirovecii. This is because routine testing with broad-range PCR adds little diagnostic value and is not cost-effective.10 However, broad-range PCR is useful when initial stains are positive for the presence of fungi, but subsequent cultures or other diagnostics are negative.23 For detecting Cryptococcus, a blood, urine, or cerebrospinal fluid sample can detect the Cryptococcus antigen with a sensitivity of 80% to 100%.23 For detecting Histoplasma or Blastomyces, UATs are the first test, with a PCR utilized for confirmation of infection.
Other tests that are not used frequently but could improve future diagnostic accuracy include 18s ribosomal RNA (most useful when organisms are visualized on microscopic stains)23 and next-generation sequencing (NGS). NGS extracts nucleic acids from a clinical specimen by unbiased (universal primers) or targeted (specific primers) sequencing and is most sensitive when fungi are visualized on stains.23
Risk Factors for Superimposed, Multi-Organism Pneumonia
Severe viral infections, especially influenza and COVID-19,23 damage the epithelium and impair immunity, predisposing patients to bacterial and/or fungal invasion. Patient-specific risk factors for coinfection include age of at least 65 years, concomitant chronic obstructive pulmonary disease/asthma, uncontrolled diabetes, immunosuppression, mechanical ventilation, or high-dose corticosteroids.3 Common pathogens include S. pneumoniae, S. aureus, Haemophilus influenzae, gram-negative bacteria in the ICU, Aspergillus, and mucormycosis.23 For patients who are not recovering or are clinically worsening despite appropriate therapy, coinfection should be considered.
Limitations and Future Directions
Rapid diagnostics face cost, access, and interpretation challenges, as evidenced by the recommendation against the routine use of NAAT-based respiratory panels in patients with CAP by the ATS/IDSA 2019 CAP guidelines.9 Differences between colonization and infection, along with incomplete fungal identification, also remain as lingering issues. Thus, future directions for diagnostic development include host transcriptomic assays, increased use of metagenomics NGS, integrated diagnostic algorithms, and expanded panels with resistance detection. Further, diagnostics are needed to determine more efficient ways for optimizing preventive methods (eg, vaccines, prophylaxis) against pneumonia pathogens.5 Overall, integrating molecular diagnostics, antigen testing, and biomarkers enable clinicians to identify fungal, viral, and bacterial pneumonia more accurately.
References
- Fernández-Ruiz M, et al. Enferm Infecc Microbiol Clin (Engl Ed). 2024;42(8):442-452.
- Kim P, et al. Infect Drug Resist. 2022;15:2219-2228.
- Vaughn VM, et al. JAMA. 2024;332(15):1282-1295.
- Gupta AB, et al. JAMA Intern Med. 2024;184(5):548-556.
- Chen L, et al. Ann Med. 2024;56(1):2399320.
- Abbott. AFINION CRP. Accessed December 22, 2025. globalpointofcare.abbott/ww/en/product-details/afinion-crp.html
- Miyashita N. Respir Investig. 2022;60(1):56-67.
- Thermo Fisher Scientific. B•R•A•H•M•S PCT (Procalcitonin). Accessed December 22, 2025. thermofisher.com/ infectious-diseases/ us/ en/ procalcitonin.html
- Metlay JP, et al. Am J Respir Crit Care Med. 2019;200(7):e45-e67.
- Martin-Loeches I, et al. Intensive Care Med. 2023;49(6):615-632.
- Azar MM. Chest. 2024;165(3):559-572.
- bioMérieux. BIOFIRE® Respiratory 2.1 (RP2.1) Panel. Accessed December 22, 2025. biomerieux.com/ us/ en/ our-offer/ clinical-products/ biofire-respiratory-panels.html
- Cepheid. Xpert® Xpress Respiratory Tests. Accessed December 22, 2025. cepheid.com/ en-US/ tests/ respiratory.html
- Roche Diagnostics. cobas® eplex system. Accessed December 22, 2025. diagnostics.roche.com/ global/ en/ products/ systems/ cobas-eplex-system-sys-447.html
- Roche Diagnostics. cobas® liat system. Accessed December 22, 2025. diagnostics.roche.com/ us/ en/ products/ instruments/ cobas-liat-ins-6050.html
- Qiagen. QIAstat-Dx US. Accessed December 22, 2025. qiagen.com/ us/ products/ diagnostics-and-clinical-research/ infectious-disease/ qiastat-dx-syndromic-testing/ qiastat-dx-na
- Fisher Scientific. Abbott™ ID NOW™ COVID-19 Assay Kit. Accessed December 22, 2025. fishersci.com/ shop/ products/ id-now-covid-19-assay-kit/ 23046650
- Quidel Ortho. SOFIATM Platform. Accessed December 22, 2025. quidelortho.com/ global/ en/ products/ sofia-platform
- Cardinal Health/Abbott. Urinary antigen testing in community acquired pneumonia (CAP): BinaxNOW™ Streptococcus pneumoniae and Legionella. Know the cause now. Accessed December 22, 2025. cardinalhealth.com/ content/ dam/ corp/ web/ documents/ literature/ abbott-strep-pneumoniae-urinary-antigen-card.pdf
- Trinity Biohealth. Uni-GoldTM. Accessed December 22, 2025. trinitybiotech.com/ area/ uni-gold/
- Abbott. BinaxNOWTM Legionella Urinary Antigen Card. Accessed December 22, 2025. globalpointofcare.abbott/us/en/product-details/binaxnow-legionella-us.html
- Fisher HealthCare. Alere BinaxNOW® Legionella. Accessed December 22, 2025. static.fishersci.eu/content/dam/fishersci/en_US/documents/programs/healthcare/technical-documents/data-sheets/fisher-healthcare-alere-binaxnow-legionella-data-sheet.pdf
- Bai L, et al. Diagnostics (Basel). 2023;13(2):280.
- Ferraiuolo S, et al. Respir Investig. 2025;63(6):1221-1228.
Copyright © 2026 McMahon Publishing, 545 West 45th Street, New York, NY 10036. Printed in the USA. All rights reserved, including the right of reproduction, in whole or in part, in any form.

Download to read this article in PDF document:![]() Diagnostic Strategies to Assist in Community-Acquired Pneumonia Management
Diagnostic Strategies to Assist in Community-Acquired Pneumonia Management
This article is from the February 2026 print issue.